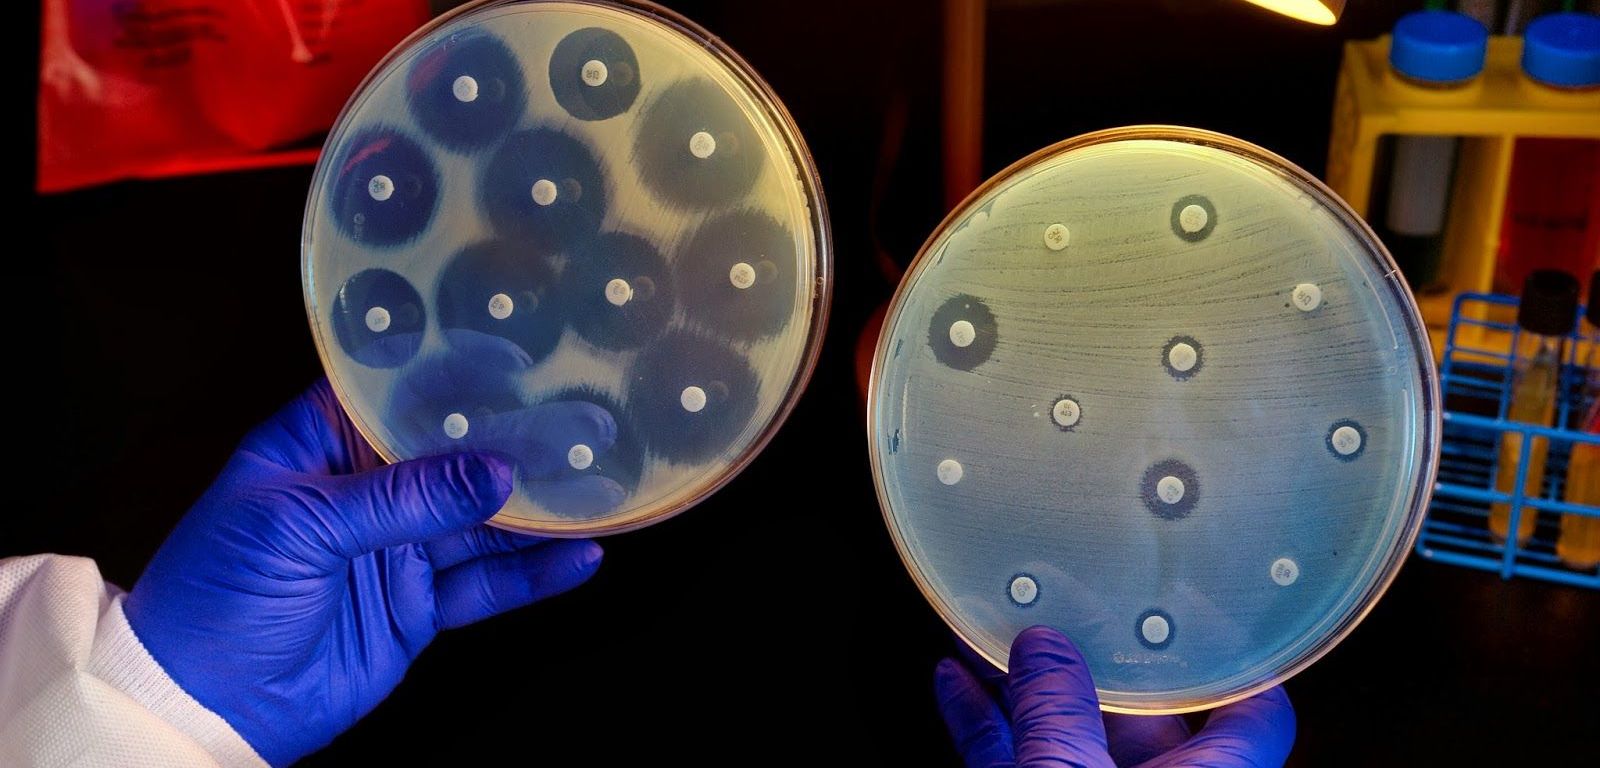

Las bacterias son organismos que se encuentran en casi todas las partes de la Tierra, son vitales para los ecosistemas del planeta. Algunas especies pueden vivir en condiciones realmente extremas de temperatura y presión.
Nuestro cuerpo está lleno de bacterias, se estima que contiene más bacterias que células humanas. La mayoría de las bacterias presentes en el organismo no nos causan daño alguno, al contrario, algunas son beneficiosas. Sin embargo, una pequeña cantidad de especies son causantes de enfermedades.

¿Cómo podemos combatir a las bacterias?
Para prevenir y tratar las infecciones bacterianas, se utilizan antibióticos, la introducción de estos en la práctica clínica es una de las intervenciones más importantes para el control de las enfermedades infecciosas y una revolución para la medicina, que ha permitido salvar millones de vidas.

Existen los Programas de Optimización del uso de Antibióticos (PROA), los cuales se implementan para optimizar los tratamientos antimicrobianos y así alcanzar los objetivos clínicos, minimizando los efectos indeseables, entre los cuales se incluye la selección de bacterias resistentes.
Se ha demostrado que la implantación de un PROA con una metodología no restrictiva logra una mejora significativa en las prescripciones y una reducción del consumo, siendo además muy aceptado por los médicos prescriptores.
¿Qué es la resistencia?
A pesar de lo beneficiosos que han sido los antibióticos para la humanidad, existe una amenaza enorme que deteriora la eficacia de estos: la resistencia bacteriana a los antibióticos, la cual podemos definir como la capacidad de una bacteria para sobrevivir en concentraciones de antibiótico que inhiben/matan a otras de la misma especie.
Las bacterias pueden mutar por el uso de estos fármacos, lo que deriva en resistencia, esto ocurre cuando las bacterias ya no responden a los antibióticos creados para eliminarlos, por lo que siguen multiplicándose. Son las bacterias quienes se vuelven resistentes a los antibióticos, no los humanos ni los animales. Si bien la resistencia a los antibióticos es un fenómeno natural, el uso indebido de estos fármacos en el ser humano y los animales está acelerando el proceso.

Al poco de introducirse la penicilina en la práctica clínica la gran mayoría de las cepas de Staphylococcus aureus eran sensibles, actualmente lo son menos del 5-10%, lo cual resulta preocupante.
Las bacterias constantemente encuentran nuevas formas de evitar los efectos de los antibióticos utilizados para tratar las infecciones que ocasionan, por lo que las infecciones que provocan al ser resistentes son difíciles o incluso imposibles de tratar, en muchos casos, las infecciones resistentes a los antibióticos ocasionan que se incrementen los costos médicos, que se prolonguen las estancias hospitalarias y que aumente la mortalidad.
La resistencia a los antibióticos se acelera con el uso indebido y abusivo de estos fármacos y con las deficiencias de la prevención y control de las infecciones.
Hoy en día, es una de las mayores amenazas para la salud mundial, la seguridad alimentaria y el desarrollo, puede afectar a cualquier persona, sin importar su edad o el país en el que viva.
¿Son malos los antibióticos?
No, en lo absoluto, los antibióticos han contribuido significativamente al progreso en campos como los trasplantes de órganos sólidos y de progenitores hematopoyéticos (procedimiento terapéutico utilizado en tumores malignos o enfermedades con una alteración de la función de la médula ósea), la supervivencia de prematuros e inmunodeprimidos (naturales o por terapias farmacológicas), la cirugía de material protésico y los catéteres vasculares, donde las infecciones suelen ser comunes e importantes. Han permitido que la esperanza de vida de la población sea mayor.

Entonces, ¿cuál es el problema?
La adaptabilidad de las bacterias se debe a su plasticidad genética y su rápida replicación. La resistencia bacteriana a los antibióticos es inevitable, sin embargo, se puede retrasar; esta puede ser reversible o casi cuando es rara, pero si es común resulta difícil; vivimos en un mundo globalizado donde es más difícil controlarla, es una crisis global en la que no son suficientes medidas nacionales o locales, día a día aparecen y se propagan en todo el mundo nuevos mecanismos de resistencia que ponen en peligro nuestra capacidad para tratar las enfermedades infecciosas comunes.
Si bien no podemos evitar el uso de antibióticos, podemos evitar hacerlo de forma excesiva e inadecuada, ya que este último es uno de los factores que contribuye al problema de la resistencia; el adecuado también, pero el primero es potencialmente mejorable.

En algunos países inclusive se podían conseguir antibióticos sin receta, lo que generaba una automedicación poco responsable. Al carecer de ciertas normativas y regulaciones, el personal sanitario y veterinario tiende a prescribirlos y la población general a consumirlos en exceso. Resulta imprescindible cambiar la forma de prescribir y utilizar los antibióticos, ya que, sin importar que se desarrollen nuevos medicamentos, si no se modifican los comportamientos actuales, la resistencia a los antibióticos continuará siendo una amenaza grave.
Los cambios de comportamiento deben incluir también medidas que tengan como propósito reducir la propagación de las infecciones, a través de la vacunación, el lavado de las manos, la seguridad de las relaciones sexuales y una buena higiene alimentaria.
¿Qué podemos hacer para prevenir y controlar la propagación de la resistencia a antibióticos?
La Organización Mundial de la Salud (OMS) recomienda a la población en general:
- Tomar antibióticos solo cuando los prescribe un profesional sanitario certificado.
- Seguir las instrucciones de los profesionales sanitarios respecto al tratamiento.
- No pedir antibióticos a los profesionales sanitarios si dicen que no son necesarios.
- No automedicarse con los antibióticos que le hayan sobrado a otros.
- Tener buenas prácticas de higiene, como: lavado frecuente de manos, condiciones higiénicas al preparar alimentos, evitar contacto cercano con enfermos, medidas de protección en las relaciones sexuales y tener completo el esquema de vacunación.
- Procurar la inocuidad de los alimentos de la OMS: mantener la limpieza; separar alimentos crudos y cocinados; cocinar completamente, mantener los alimentos a temperaturas seguras, usar agua y materias primas inocuas; así como elegir alimentos para cuya producción no se hayan utilizado antibióticos con el fin de estimular el crecimiento ni de prevenir enfermedades en animales sanos.